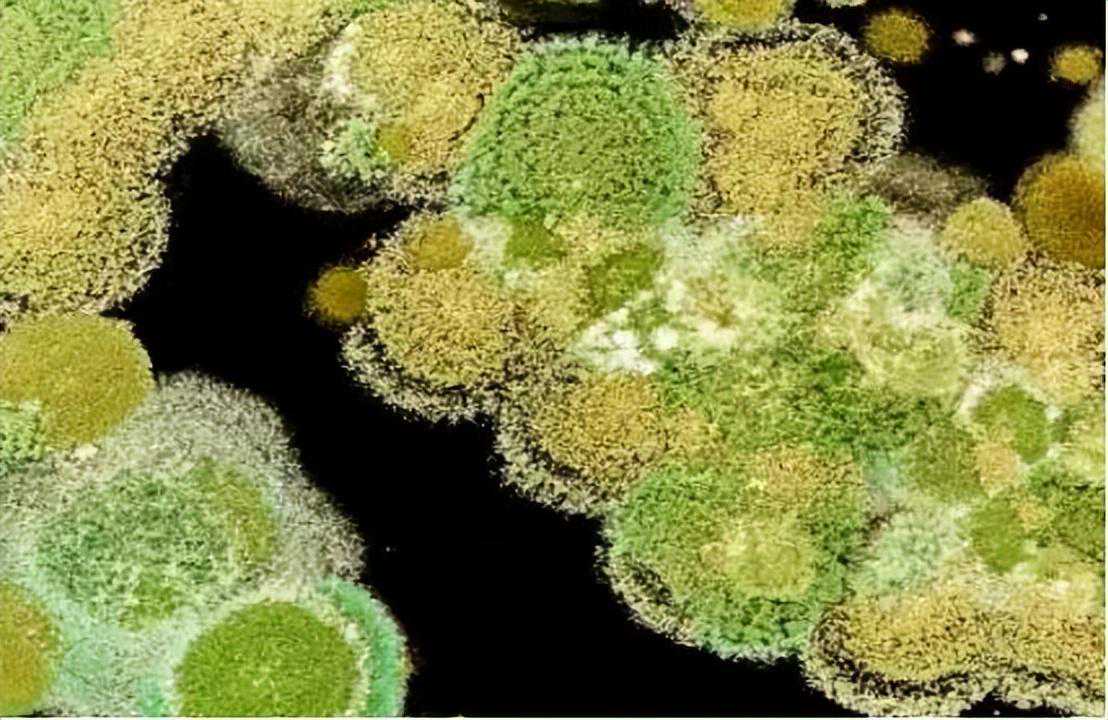

编辑|陈住气
民以食为天,而馒头作为人们日常生活中的常备食物,一直以来都备受大家的青睐,甚至大多数家庭每次都是制作一大锅,吃不完就冷冻起来,留着下次继续吃,简单又省事。

对此,不少网友表示:“馒头在冰箱冷冻不可以超过三天,不仅对身体不好,还会产生一种黄曲霉素的毒素,从而引发癌症!”而央视平台更是针对这一说法做了实验,结果震惊不少长辈群体。

长时间的冷冻馒头真的会致癌吗?官方的实验结果又是怎样的呢?

在我们日常生活中,饮食和我们的生命安全存在着紧密的联系,毕竟人们每天都通过饮食来维持自己的热量和能量,从而保证体内器官和细胞的正常运作。

为此,食物安全性对我们每一个人而言,都有着至关重要的作用,不然稍有不慎就会引起一些不可避免的后果,尤其是当食物储藏不当,导致食物出现发霉、变质等现象,都将得不偿失。

其实对于大部分居家生活的群体而言,很多时候大家做的饭菜都会出现量多,一顿吃不完的现象,这样一来就常常需要将食物搁置到下一顿,直到家里吃完为止。

但对于很多讲究的群体来说,他们通常在制作食物时,都会掌握好一定的用量,通常情况下都是刚刚好的状态,他们秉持着“不多吃、不浪费”的原则,哪怕是不够吃也不能浪费。

而随着次数增加后,他们在经过多次恰好的制作后,对于自家的一个饭菜用量,也有了一定的掌握,之所以如此,也是因为他们深知吃过夜饭菜不太友好。

只因,很多人在将大量的食物储存时,除去会有一些食物上的浪费以外,还有很多搁置时间较长,导致食物出现发霉的现象,尤其是在天热的情况下,这种情况更是屡见不鲜。

在生活中,很多时候在饭菜吃不完,或者买的东西数量过多,因为家中人数过少或者是没有吃完时,大家最后都将食物按照个人习惯放在菜桌上,再或者是放在自己都感觉不起眼的位置。

待自己后面想起来时,食物往往已经出现发霉,味道变馊、或者氧化质变的现象,甚至有时候虽然没有明显的味道,一些老人就会想着不想浪费的心态,侥幸去食用。

但其实这样的现象和操作都是不建议且不认可的,毕竟一些食物如果已经出现发霉的现象,那么食用者轻则会出现一些腹痛、胃痛等现象,从而引起肠胃不适,严重还会出现食物中毒。

毕竟当食物储存方式和时间不当时,食物本身就会出现许多细菌,像一些发霉的霉菌和大量细菌都会进入人体内,不仅影响肠道蠕动,还会造成大量的肠胃菌群,从而出现消化不良。

甚至还有事态严重时,会产生一些大量的病毒,如果人体长期保持这样的不良习惯,很容易给自身带来生命危险,虽然食物中毒有时候经过医治和洗胃等方式,可以急诊治疗。

但很多时候,病症都是不等人的,所以为了保证我们的身体健康,最好还是减少这样的现象发生,毕竟很多时候,这些不良行为带来的后果我们都无法估量。

而馒头更是如此,很多人认为:“馒头更不应该在冰箱中进行冷冻,否则将会产生大量的毒素,从而引起癌变”,但面对这样的说法,各路网友也是众说纷纭,对此央视平台更是以实验的形式出面回应

馒头本就是我们生活中最常见且最基本的食物之一,无论是我国北方还是南方地区,都会蒸一些馒头当做家中的食物,毕竟这也是每餐中不可或缺的存在。

但正是因为馒头的制作过程稍微有些繁琐,再加上还是生活中的必备食物之一,所以大多数家庭每次在蒸馒头时,都会去批量蒸馒头,即便是不做饭常常购买馒头的家庭,也会一次性买上几袋。

可对于大多数家庭而言,通常一顿两顿是吃不完这些馒头的,尤其是在农村,更是有不少长辈会制作一大锅的馒头,如果家中只有一些中老男人,食用周期也是非常长的。

而我们日常中储存食物的方式,无非就是常温、冷藏或冷冻,而无论是哪一种,都不建议储存过长的时间,然而在夏天因为天气炎热,大多数人会将馒头放进冰箱冷冻起来。

而针对这一现象,不少网友纷纷表示:“如果将馒头冷冻超过三天,将会引起一定的霉变反应和对应的毒素,从而很容易引起人体癌变!”

对于这样的说法,不少人也为此开始议论纷纷,毕竟生活中那些冷冻超过三天的群体也不在少数,如果只是将馒头冷冻三天,一定会引起众多网友的热议。

之所以有这样的说法,也是因为他们认为冷冻时间过长,食物就会产生一种黄曲霉的毒素,毒素不仅会引起一定的癌细胞现象,甚至还会给人体形成一种肠胃癌、肝癌和食道癌等后果。

正是因为大众对这样的说法有着一件保留的说法,所以央视财经频道也针对这一观点,在《是真的吗》的节目上邀请相关领域的专家对此进行实验和论证。

而钟凯作为科信食频与营养信息交流中心的副主任,在领域内也有着一定的声望,于是便被节目邀请坐阵,他们不仅针对馒头冷冻三天,是否会产生毒素并致癌一事展开论证。

同时还分不同的小组对不同环境和不同储藏方式来进行试验,他们将同样材料制作而成的馒头,在同样的时间分别在常温等三种形式下进行保存。

不过在实验三天后,无论是哪种形式的馒头,都并没有出现发霉等现象,但当实验进行到15天时,常温储藏的馒头便出现发霉、变质的现象,而冷藏和冷冻的馒头并未出现。
不仅如此,他们还将这些经过测试的馒头都统一送到相关检测中心进行检测,结果表明也只是常温储藏的发霉馒头出现有大量的黄曲霉毒素,而冷藏和冷冻的馒头并没有毒素现象。

所以经过这一试验,专家也直接解释并否定了“馒头冷冻三天会致癌”的说法,不过专家也对此表示,无论是哪种储藏方式,都不建议保留太长的时间,不然终会影响一定的营养价值和口感。

此外他还表示,黄曲霉素产生的现象是经过一定条件的,不仅需要长时间储藏在28度以上的温度,同时还要具备80%的湿度,只有两种情况下,才会产生这样的现象。

而这样的情况在日常生活中,是很少同时具备的,但并不代表在特种环境下,就没有这样的现象产生,所以无论是馒头还是其他生活食品,都最好保持现吃先做的习惯。

毕竟在生活中,食品安全的重要性还是有着一定的影响的,稍有不慎不仅会给健康带来一定影响,同时也会影响我们的生活质量。

饮食安全是我们日常生活中的重要环节之一,随着时代的迅速发展和人们生活水平改善,人们对食物需求也逐渐有许多的要求,甚至还有不少家庭开始逐渐对食品质量进行严格把控。

毕竟当下社会下,原来越多的食品会有大量的添加剂,而这也是人们不想看到的景象,所以更多时候都会去吃一些自己种植的绿色蔬菜,不仅营养成分极高还十分安全。

所以很多家庭不仅会买一些纯绿色食品,还会在制作过程中,对水果和蔬菜有着极高的清洗过程,他们会采用专门的食品洗涤剂或者是一些苏打粉、淀粉等取清洗多遍。

就连在冰箱和日常的储藏过程中,他们都会将不同类型的食品用保鲜膜和一定的包装盒进行分类收纳,这样的话不仅避免食品窜味,同时也能避免食品在同类型一块时,加速氧化变质。

当今社会人们不仅对自己身要求越来越高,就连生活质量也是越来越完善,而食品作为长时间与人体接触并作为能量输送的存在,自然有着一定的作用。

所以在食品安全上,都要保持一定的警惕和干净卫生,不然无论是大人还是小孩,都会出现一些不可避免的身体伤害,届时都会消耗一定的财力和混乱的生活状态。
写到最后生活中的食物储存,或许看起来是一件很小且不经意间的事情,但大多数情况都是这些小细节,从而隐藏一些巨大的食品安全隐患,所以还是谨慎些为好。





